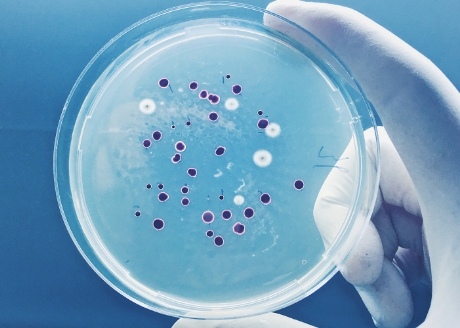
Działanie antyseptyczne

- Bricomarché
- >Zwierzęta
- Okazje online
- Wyprzedaż Online
- Wielkanoc
- Wszystkich Świętych
- Halloween
- Promocje
- Sylwester/Nowy Rok
- Hobby
- Ogród
- Elektryka
- Farby i lakiery
- Łazienka
- Stolarka
- Oświetlenie
- Ogrzewanie i wentylacja
- Hydraulika
- Dekoracje wnętrz
- Narzędzia
- Artykuły gospodarcze
- Budowanie
- Świat dziecka
- Kuchnia
- Panele podłogowe
- Płytki i gresy
- Przechowywanie
- Boże Narodzenie
- >Maty absorbujące 60 x 60 cm - 10 sztuk

Maty absorbujące 60 x 60 cm - 10 sztuk
Opis produktu

Maty absorbujące 60 x 60 cm - 10 sztuk
do bezpiecznego i sprawnego szkolenia w domu
Maty absorbujące odznaczają się wysoką chłonnością, która zapobiega wyciekaniu płynów na zewnątrz. Ze względu na wysoką jakość wykonania oraz specjalnie opracowaną strukturę maty są odporne na rozdarcia i zniszczenia. Dodatkową zaletą jest obecność ekstraktu z zielonej herbaty o działaniu septycznym. Maty absorbujące sprawdzą się w domu, a także w podróży, gdy zwierzak jest transportowany w klatce lub boksie. Zestaw obejmuje podkłady, które są przeznaczone dla szczeniąt, psich seniorów oraz zwierzaków, mających problem z nietrzymaniem moczu.

Wchłaniają bardzo duże ilości płynów.

Odporność na rozerwanie dzięki specjalnie opracowanej strukturze.

Ekstrakt z zielonej herbaty działa antyseptycznie.

Świetnie sprawdzą się zarówno w przypadku szczeniąt, jak i dorosłych psów.

Wysoka absorpcja płynów
Doskonała chłonność
Wybierz super chłonność. Maty odznaczają się wysoką absorpcją płynów. Produkt skutecznie zatrzymuje płyny, równocześnie sprawiając, że łapy psiaka pozostają suche.

Odporność na rozerwanie
Doskonała wytrzymałość
Maty absorbujące wyróżniają się specjalnie opracowaną strukturą. Dzięki temu są one odporne na rozdarcia i zniszczenia. Nie musisz więc martwić się, że już po pierwszym użyciu mata będzie wymagała wymiany.
Działanie antyseptyczne
Wysokiej jakości wykonanie
Przekonaj się, że mając szczeniaka lub psa seniora, można utrzymać czystość w domu. Maty posiadają ochronę, która skutecznie zapobiega wyciekaniu płynów oraz ulatnianiu się woni moczu na zewnątrz.

Doskonałe dla psów w każdym wieku
W trosce o każdego pupila
Maty absorbujące pomogą Ci nauczyć szczeniaczka, gdzie powinien się załatwiać, by nie powodować szkód w Twoim domu. Doskonale sprawdzą się również w przypadku starszych i schorowanych psów, które mają problemy z kontrolowaniem oddawania moczu.
Specyfikacja
- EAN3336024770016
- Informacje o producencieZolux Polska Sp. z o.o., Łężki 10A, 99-200 Poddębice, [email protected]
- Opakowanie10
- Typmata
- Zastosowanienauka czystości
Możesz potrzebować
Podobne produkty
- Data malejąco
- Data rosnąco
- Ocena malejąco
- Ocena rosnąco
- Najbardziej przydatne
- Najmniej przydatne
- Brak wyników
- Brak wyników
0
Na podstawie 0 opinii
Porady
